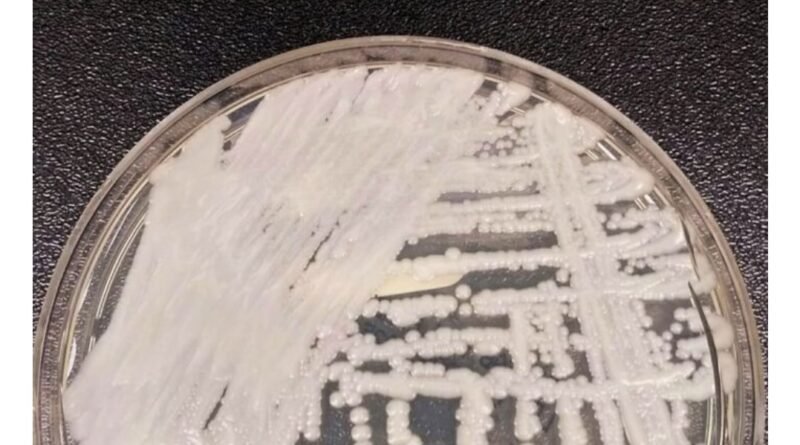

Superfungo chega ao Brasil: O Candida auris e já tem caso confirmado
O estado de São Paulo confirmou o seu primeiro caso do superfungo Candida auris em um paciente neonatal do Hospital da Mulher Prof. Dr. José Aristodemo Pinotti, da Unicamp (Universidade Estadual de Campinas), na cidade de Campinas.

De acordo com informações da Secretaria de Saúde, a presença do fungo foi detectada no dia 18 de maio, após exames realizados em um paciente, que está sendo acompanhado por equipe médica, tendo boa evolução clínica. O nome dele não foi informado.
Agente patológico
Em nota, o estado informou que, até o momento, nenhum profissional ou outro paciente foi diagnosticado com o agente patológico e que a unidade seguirá com novos rastreamentos e reforço das medidas já adotadas.
“Todas as medidas de contenção da disseminação estão sendo adotadas, com ampla investigação em relação aos profissionais e pacientes do hospital”, informa o comunicado.
Segundo o Ministério da Saúde, o superfungo Candida auris foi identificado pela primeira vez como causador de doença em humanos em 2009, no Japão.
A levedura – tipo de fungo que possui apenas uma célula – causa grande preocupação nas autoridades sanitárias por ser resistente diante da maioria dos fungicidas existentes. Em alguns casos, a todos. Isso levou a espécie a receber o apelido de superfungo.
Share.

